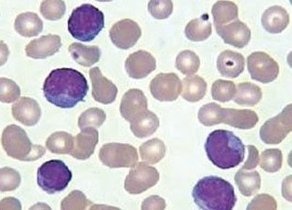
异型淋巴细胞_360百科

据了解,如果出现偏高或者偏低就属异常,那么血常规淋巴细胞偏高要紧吗?下面一起来了解。血常规 血常规
患者信息:女 24岁 上海 浦东新区 病情描述(发病时间、主要症状等):连续两年体检都是淋巴细胞比例偏高
淋巴细胞具有产生和运载抗体、防御病毒感染的作用。淋巴细胞百分比率为临床化验血液常规检测,正常值为20.0
提供全面的“淋巴细胞”相关文献(论文)下载,论文摘要免费查询,淋巴细胞论文全文下载提供PDF格式文件。
T淋巴细胞来源于骨髓的多能干细胞(胚胎期则来源于卵黄囊和肝)。在<a class=
T淋巴细胞来源于骨髓的多能干细胞(胚胎期则来源于卵黄囊和肝)。在人体胚胎期和初生期,骨髓中的一部分
B淋巴细胞亦可简称B细胞,来源于骨髓的多能干细胞。B淋巴细胞的祖细胞存在于胎肝(胚胎小鼠14天或通顺儿8-9

急性淋巴细胞白血病_互动百科
288x220 - 12KB - JPEG

急性非淋巴细胞白血病
665x480 - 58KB - JPEG

叶核嗜中性粒细胞
300x158 - 9KB - JPEG

淋巴细胞归巢_互动百科
300x199 - 116KB - PNG

淋巴细胞
293x220 - 14KB - JPEG

淋巴细胞
485x400 - 58KB - JPEG

T淋巴细胞
300x240 - 12KB - JPEG
异型淋巴细胞_360百科
292x210 - 14KB - JPEG

T淋巴细胞-+搜搜百科
500x328 - 56KB - JPEG

b淋巴细胞+-+搜搜百科
426x437 - 24KB - JPEG

《自然》发文纪念B淋巴细胞50年-科普中国
600x600 - 248KB - JPEG

B淋巴细胞
292x300 - 13KB - JPEG

淋巴细胞
430x480 - 21KB - JPEG

【淋巴细胞比率偏高】【图】淋巴细胞比率偏高
450x300 - 32KB - JPEG

免疫细胞B淋巴细胞
576x460 - 76KB - JPEG